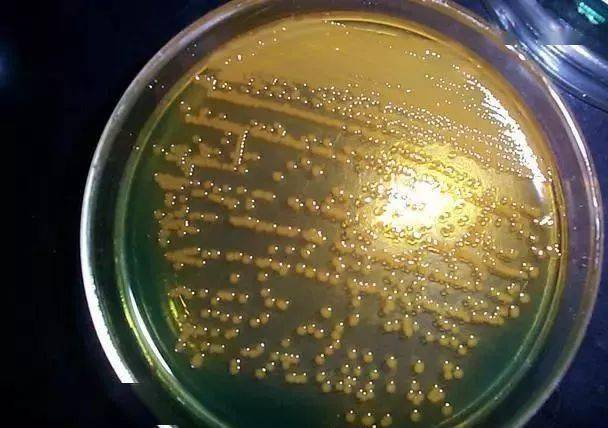
池塘底部一些饲料,残饵和死藻上附着大量的副溶血弧菌,哈维氏弧菌
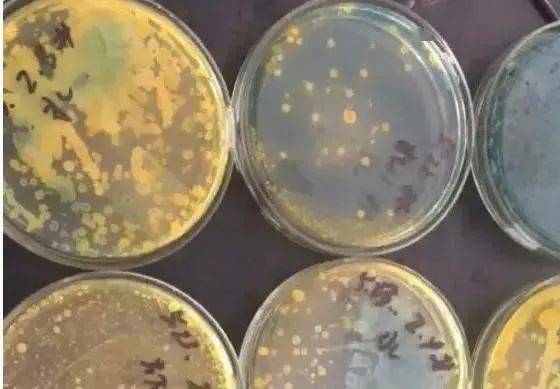
作用,具有极强的穿透力和渗透性,能够破坏细菌的细胞膜,对哈氏弧菌,副

哈氏弧菌

弧菌
图片尺寸756x504
池塘底部一些饲料,残饵和死藻上附着大量的副溶血弧菌,哈维氏弧菌
图片尺寸608x428
令养殖户一直头疼的有害菌——弧菌,到底该如何搞定
图片尺寸640x594
微生物显微图
图片尺寸500x400
一株致病性海洋哈氏弧菌及其应用的制作方法
图片尺寸973x1000
小龙虾养殖务必要小心池塘里的弧菌!否则雨后天晴就死虾!
图片尺寸554x585
parahemolyticus)副溶血性弧菌也称为肠炎弧菌,为革兰氏阴性杆菌,呈弧
图片尺寸1024x1024
弧菌给我们养虾造成那么大的损失到底该如何处理弧菌
图片尺寸640x1138
哈维弧菌与发光细菌疾病有关,鳗弧菌是攻击幼虾并导致大量死亡的主要
图片尺寸588x670
弧菌形态介绍图
图片尺寸373x250
哈维氏弧菌哈维氏弧菌是引起水产动物特别是海水鱼类流行性疾病的一种
图片尺寸625x280
霍乱弧菌是人类霍乱的病原体,霍乱是一种古老且流行广泛的烈性传染病
图片尺寸1080x829
虾的主要致菌为:溶藻弧菌,副溶血弧菌,哈维氏弧菌,霍乱弧菌等.
图片尺寸640x776
比眼镜蛇毒还强80倍的剧毒为何突然出现在吃了几十年的海鲜里
图片尺寸600x375
作用,具有极强的穿透力和渗透性,能够破坏细菌的细胞膜,对哈氏弧菌,副
图片尺寸560x389
给你一份弧菌的科普知识,赶快看看吧
图片尺寸640x1138
想知道怎么预防和治疗池塘里的弧菌吗?
图片尺寸1002x461
霍乱弧菌图片
图片尺寸400x300
细菌肺炎克雷伯氏菌是一种革兰氏阴性,不运动,包裹,乳糖发酵,兼性厌氧
图片尺寸612x459
弧菌病害防治:水产养殖中一种不得不防的致病菌
图片尺寸1200x855